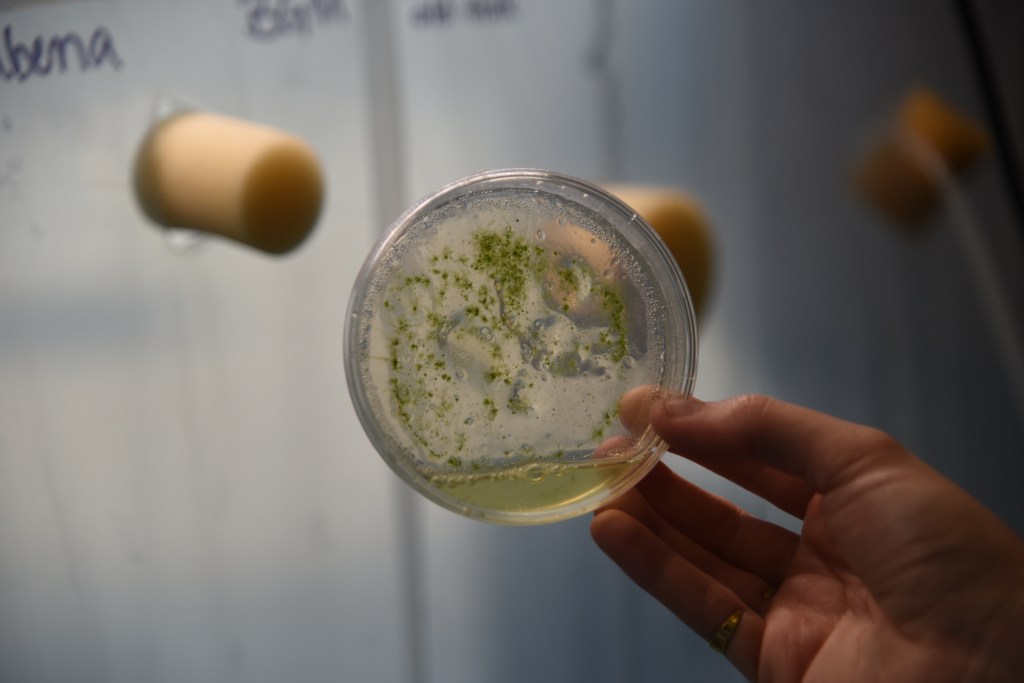

Nou
Skin and mind biobooster
Nou is a dual-function bio-booster that combines skincare and nutrition. It uses microalgae bioactive compounds to act as a perfume preserving skin microbiome, and as a fruity energy booster rich in vitamins when ingested. Made with just two microalgae species and rainwater, Nou promotes sustainable wellness.
Harvesting rainwater
When observed under a microscope, rainwater reveals microalgae, organisms, and bacteria.
It is used as a medium for cultivating microalgae.


Prototype
An advanced system that captures rainwater, humidity, and condensation, integrated with photobioreactors to cultivate the microalgae species Dunaliella salina and Haematococcus pluvialis.


Microalgae
Microalgae are nutrient-rich organisms packed with
proteins, vitamins, minerals, antioxidants, and essential fatty acids.
DUNALIELLA SALINA
Carotenoids protect cells from oxidative stress, support skin health, strengthen the immune system, and are rich in vitamin A.



HAEMATOCOCCUS PLUVIALIS
Under stress, Haematococcus pluvialis turns red and produces astaxanthin, a powerful antioxidant that contributes significantly to skin protection.



Process

CREDITS
A project in collaboration with MA Biodesign @mabiodesign,
Central Saint Martins @csm_news and @lvmh & @maisonzero
Team:
Weronika Turowska
Elie Al-Marji
Andrea Carrera
Teresa Colombo
Shom Shah
Xinnuo Du
Peichin Lin
Fiona Fu
Yingying Lu

